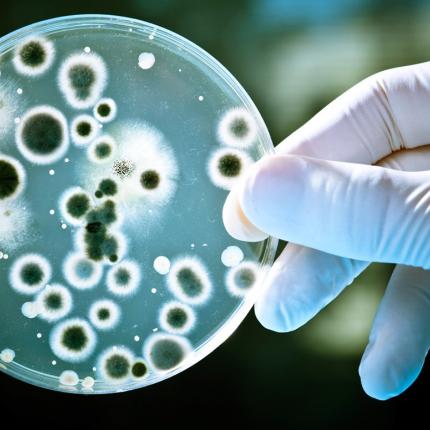
βακτήρια,τριβλίο

Φόβους ότι η ανθρωπότητα πλησιάζει ανεπιστρεπτί στην εποχή μετά τα αντιβιοτικά γεννά στην παγκόσμια επιστημονική κοινότητα
Ένας άνθρωπος, κατά μέσο όρο, χρησιμοποιεί 16.000 λέξεις ημερησίως.
Εκδήλωση με θέμα τα εμβόλια, τη σωστή και έγκαιρη πρόληψη των πολιτών, οργανώνει ο Ιατρικός Σύλλογος Ηρακλείου σε...
«Το φαγητό εκτός σπιτιού συνδέεται με τη χαμηλή διατροφική αξία και την παχυσαρκία
Η ομάδα φίλων του Δρ.Κωνσταντίνου Μουρούτη στo Ηράκλειο διοργανώνει τριήμερο ανοικτό σεμινάριο υγείας στις 27-28-29 Νοεμβρ
Τα δημητριακά ολικής άλεσης περιέχουν βιταμίνες του συμπλέγματος Β, φυλλικό οξύ, βιταμίνη Ε σε περισσότερο ποσοστό από τα
Επιστήμονες στη Σουηδία ανακοίνωσαν ότι ανέπτυξαν ένα τεστ αίματος για τη διάγνωση του επιθετικού καρκίνου του προστάτη, τ
Σημαντική υστέρηση στις υποδομές μεταμοσχεύσεων και στους εθελοντές δότες αίματος εμφανίζει η χώρας μας, παρά τις ελπιδοφό
«Εφιαλτικές» διαστάσεις τείνουν να πάρουν σε παγκόσμιο επίπεδο οι ακρωτηριασμοί, καθώς από τις συχνότερες επιπλοκές του σα
Τα νεφρά σας είναι δύο όργανα σε σχήμα φασολιού, το καθένα περίπου στο μέγεθος της γροθιάς σας.
Σοβαρή “απειλή” για τη δημόσια υγεία παγκοσμίως αποτελεί η παχυσαρκία κατά την παιδική και εφηβική ηλικία, καθώς τόσο στην